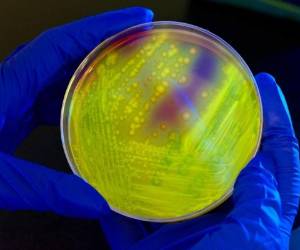

Este lunes, Nature Biotechnology publicó un estudio en donde afirma que también sería posible adaptar este tipo de tecnología para otros patógenos y toxinas alojados en cualquier individuo.
LEA: El Covid-19 puede infectar las neuronas
Ingenieros del Instituto Tecnológico de Massachusetts (MIT) y de la Universidad de Harvard han diseñado esta mascarilla que trae incorporados unos diminutos sensores desechables que se pueden acoplar a otros tapabocas faciales.
¿En qué se basan estos sensores?
Dichos sensores se fundamentan en una maquinaria celular liofilizada que el equipo de investigación había desarrollado para su uso en diagnósticos de virus como el Ébola y Zika.Según sus creadores, la mascarilla incluye un pequeño depósito de agua que es liberada al pulsar un botón justo cuando el usuario está listo para realizarse la prueba anticovid. Esta acción hace que se hidraten los componente liofilizados del sensor del covid-19 y que analizan las gotas de aliento acumuladas en el interior del mismo tapabocas.
Lo impresionante de la invención es que, los resultados (disponibles en 90 minutos) solo se muestran en el interior de la mascarilla con el objetivo de respetar la privacidad de quien la usa.
ADEMÁS: ¿Cuáles son los síntomas para saber si tienes la nueva variante delta del coronavirus?
Peter Nguyen, uno de los investigadores de Harvard, destacó que han logrado reducir 'todo un laboratorio de diagnóstico a un pequeño sensor, basado en biología sintética que funciona con cualquier mascarilla y combina la gran precisión de las pruebas de PCR con la rapidez y el bajo coste de los test de antígenos'.
Estos sensores también pueden agregarse a la ropa -como las batas de laboratorio- acción que 'podría ofrecer una nueva forma de controlar la exposición de los trabajadores sanitarios a diversos patógenos u otras amenazas', indicó el MIT en un comunicado.
Prueba
El autor principal del estudio, James Collins, señaló que han demostrado que se puede liofilizar (deshidratar) una amplia gama de 'sensores de biología sintética para detectar ácidos nucleicos virales o bacterianos, así como sustancias químicas tóxicas, incluidas las toxinas nerviosas'.El equipo de investigación ya solicitó la patente de la tecnología y espera trabajar con una empresa -hasta ahora no identificada- para seguir desarrollando los sensores.
'Lo más problable' es que la mascarilla sea la primera aplicación que podría estar disponible en el mercado, según lo manifestado por Collins.
DE INTERÉS: Fármaco para la artritis sería prometedor contra el covid-19 grave, según estudio